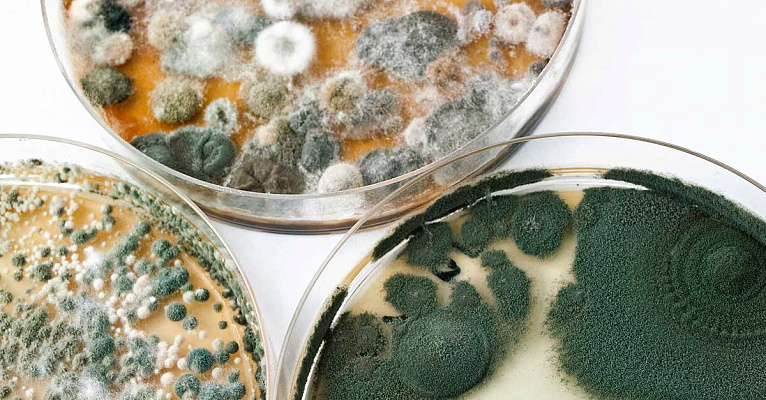

Грибок — одно из самых опасных явлений на планете. Существует огромное количество разновидностей бактерий, которые люди называют плесенью. Они очень быстро размножаются, приспосабливаются практически к любым климатическим условиям и, зачастую, несут непоправимый вред.
К сожалению, плесень проявляется не сразу. Она может быть незаметной долгие годы, но при этом размножаться и вредить окружающей среде.
Что делать, если вы заметили плесень на своём ковролине? Не спешите выбрасывать полотно! О том, как избавиться от микроорганизмов и не допустить их повторного появления мы расскажем в этой статье.
Причины появления
Основная причина появления плесени — влажность. Плохая вентиляция, холодная погода, чрезмерное использование увлажнителя и многие другие вещи могут стать ключевым помощником в развитии бактерий на вашем ковролине. Застоялый воздух, капли воды на ворсе, холод (средняя температура в комнате ниже 22-23 °С) — это отличная среда для размножения и появления бактерий.
Самая частая ситуация, которая становится причиной появления плесени, — недосушенный ковер. Влажная уборка пылесосом, химчистка или клининг вымыли ворс, просушили верх, а подложка осталась мокрой. Особенно актуально это для ковролина с длинным ворсом. Несколько недель нахождения такого покрытия в квартире, и грибок начинает развиваться.
Вторая по частоте причина — проблемы с вентиляцией и плохое отопление. Ковролин, который лежит в угловой, плохо отапливаемой комнате, обычно покрывается плесенью за несколько месяцев. Именно поэтому нельзя не учитывать показатели влажности помещения при покупке ковролина.
Чем опасна
Почему плесень так опасна? Конечно, существуют безобидные грибки, например, дрожжи. Из некоторых делают вина или сыры, а какие-то используются на закваску. Но, к сожалению, плесень, которая способна выживать в вашей квартире: на пластике, текстиле, дереве и даже бетоне, не может быть безопасной.
-
Плесень вызывает аллергические реакции.
-
Может провоцировать легочные заболевания.
-
Ухудшает проблемы с пищеварением, может вызывать аллергию.
-
Является очень мощным токсином. Вызывает отравление.
Как почистить ковролин
Самым эффективным и надежным способом является химчистка. Если вы обнаружили плесень на своем ковролине не допускайте нахождения в комнате детей и животных, постарайтесь исключить контакт с полотном, а после вызовите клининг. Специализированные службы способны устранить не только локальные проявления бактерий, но и уничтожить зародыши грибка, поэтому такой метод борьбы будет более эффективным.
Однако в случае небольших очагов плесени, бороться с ней можно самостоятельно. Вот несколько бытовых средств, способных убить вредоносные бактерии.
Уксус
Это средство имеет антисептические и противомикробные свойства. Поэтому уксус может справиться с большей частью грибков. Однако важно учитывать, что используют его лишь для точечных очагов, и после ковролин некоторое время будет иметь специфический запах.
-
Пропитайте неразбавленным уксусом плесневую часть полотна.
-
Оставьте раствор на час.
-
Смойте все большим количеством проточной тёплой воды.
-
Просушите ковролин.
При работе с уксусом важно учитывать его агрессивный состав. Работайте только в перчатках. А перед использованием уксуса убедитесь, что это не испортит ворс.
Сода
Это менее агрессивное средство. Сода способна не только устранить плесень и осветлить покрытие, но и избавить помещение от неприятного запаха. Данное вещество безопасно в применении и не вызывает аллергии, поэтому является наиболее популярным домашним способом борьбы с бактериями.
-
Приготовьте раствор: на 1 литр воды 1-2 столовые ложки соды (с горкой).
-
Нанесите раствор на ковролин с помощью губки.
-
Дождитесь полного высыхания.
-
Пропылесосьте или смахните щеткой оставшиеся кристаллы соды.
Такой метод позволяет отмыть даже крупные проявления плесени. Для этого достаточно навести необходимое количество раствора.
Раствор йода
Йод также является антисептиком, благодаря чему эффективно убивает бактерии плесени. Однако при его применении важно понимать, что вещество окрасит ворс. После такой процедуры отмыть ваш ковролин будет невозможно.
-
Приготовьте раствор: 20 капель йода на 10 литров воды.
-
Распылите раствор по ковролину или пропитайте полотно губкой.
-
Просушите текстиль.
Метод подойдет только для крупных пятен плесени и темного ковролина.
UV-лучи
Бактерии не могут размножаться и жить в сильно освещенных местах. Поэтому освещение полотна UV-фонариком или лампой для сушки гель-лака может убить небольшие очаги грибка. Это довольно эффективный метод, не оставляющий следов и неприятного запаха, однако он не подойдет, если плесень активно развивается.
Фунгициды
Это специализированная химия, предназначенная для борьбы с бактериями. Данные вещества активно используются не только в быту, но и при выращивании растений.
-
Для чистки ковролина фунгицидом придется провести демонтаж.
-
Предварительно проверьте, не несет ли препарат вреда ворсу.
-
Разводите раствор по инструкции, после приготовления нанесите его на очищаемое полотно.
-
Оставьте химикат на указанное в инструкции время.
-
Тщательно промойте ковролин теплой водой. Важно смыть остатки грибка и фунгицидов.
-
Просушите материал.
Этот вид чистки подходит для серьезных повреждений, если плесень покрывает большую часть ковролина. При работе с составом соблюдайте осторожность: используйте маску и перчатки, а также защитные очки. Некоторые из фунгицидов могут быть опасны!
В нашем магазине богатый выбор ковролина. Ознакомьтесь с ассортиментом и выбирайте подходящий именно вам ковролин, а наши консультанты всегда помогут вам с выбором!